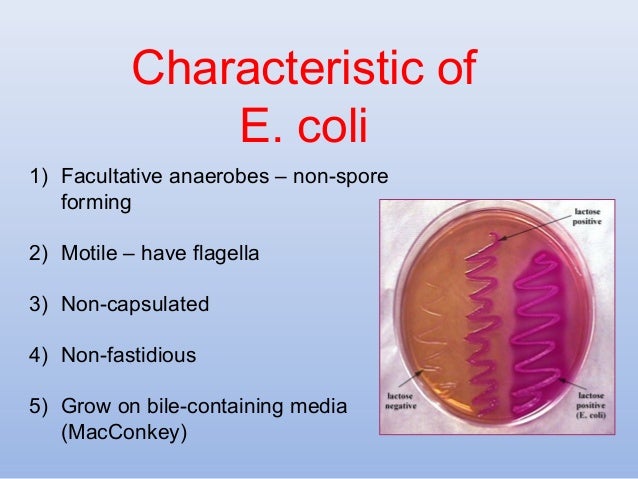

【人気ダウンロード!】 rash e coli symptoms 258878-Can e coli give you a rash
This signs and symptoms information for Ecoli food poisoning has been gathered from various sources, may not be fully accurate, and may not be the full list of Ecoli food poisoning signs or Ecoli food poisoning symptoms Furthermore, signs and symptoms of Ecoli food poisoning may vary on an individual basis for each patient66 y/o Dr Oscar Novick answered 58 years experience PediatricsPossible e coli (vomiting 1 day, diarrhea 5 days), and have a rash will rest and probiotics be sufficient, or should i go to the doctor?
Fever And Rash Infectious Disease And Antimicrobial Agents
Can e coli give you a rash
Can e coli give you a rash-Doctor's Notes on Shiga Toxin E coli 0104H4 "Shiga" toxin is a strain of the Escherichia coli (E coli) bacteria that are commonly but they can cause infections when they spread to urine or bloodThe "Shiga" toxin can invade the lining of the gut and/or produce toxins that cause damage or secretory malfunctions of gut cells, which can cause watery or bloody diarrheaSymptoms of infection with E coli 0157 typically appear 3 to 4 days after being exposed to the bacteria However, symptoms may appear as early as 24 hours or as late as 1 week later



Cat Scratch Disease Healthy Pets Healthy People Cdc
Possible e coli (vomiting 1 day, diarrhea 5 days), and have a rash will rest and probiotics be sufficient, or should i go to the doctor?Signs & Symptoms Multistate Outbreak of Shiga toxinproducing Escherichia coli O157H7 Infections Linked to Ground Beef Skip directly to site content Skip directly to page options Skip directly to AZ link Skip directly to AZ link Skip directly to AZ link Centers for Disease Control and Prevention CDC twenty four seven"how quickly can e coli grow or spread if aspirated into the lungs?" Answered by Dr Gurmukh Singh 30 minute Dobuling time E Coli and grow and divide every 30
E coli infection symptoms vary depending on the type of infection but often include watery or bloody diarrhea, severe stomach cramps, nausea, vomiting, confusion, and fatigue Symptoms may take aOne of the symptoms is a rash, which appears in three stages A blotchy red rash on the cheeks with groups of red papules After 4 days, a net of red marks may appear on the arms and trunkSeek medical attention if you observe any of these symptoms and have had a tick bite, live in an area known for Lyme disease, or have recently traveled to an area where Lyme disease occurs Untreated Lyme disease can produce a wide range of symptoms, depending on the stage of infection
Symptoms of Shiga toxinproducing E coli (STEC) infection vary for each person, but often include severe stomach cramps, diarrhea (often bloody), and vomiting Some people may have a fever, which usually is not very high (less than 101˚F/385˚C) Most people get better within 5 to 7 daysEnterohemorrhagic E Coli is a type of bacteria that causes bloody diarrhea E coli is a very common type of bacteria in the body, and it is only the OH157H7 type that causes the problem It can be found in undercooked meat and other foods;E coli O157H7 Infections Linked to Romaine Lettuce plus icon E coli O157H7 Infections Linked to Romaine Lettuce en Español Advice to Consumers, Restaurants, Retailers, and Clinicians



Contemporary Infectious Exanthems An Update Future Microbiology



Bowel Bypass Syndrome Dermnet Nz
The strains of E coli that make the toxin are sometimes called STEC, which is short for "Shiga toxinproducing E coli" One especially bad strain, O157H7, can make you very sick It causesSymptoms of infection with E coli 0157 typically appear 3 to 4 days after being exposed to the bacteria However, symptoms may appear as early as 24 hours or as late as 1 week laterE coli O157H7 and other strains that cause intestinal sickness are called Shiga toxin–producing E coli (STEC) after the toxin that they produce Symptoms of intestinal infection include



Symptoms Of E Coli Infection About E Coli



Escherichia Coli Infections American Academy Of Pediatrics
Ground beef is a common source of E coli outbreaks Although some infections are extremely mild, others can be deadly E coli symptoms can be brutal, and often include bloody diarrhea and vomiting, along with severe stomach cramps Symptoms usually begin three to four days after eating tainted foodThis type of UTI is usually caused by Escherichia coli (E coli), a type of bacteria commonly found in the gastrointestinal (GI) tract However, sometimes other bacteria are responsible Sexual intercourse may lead to cystitis, but you don't have to be sexually active to develop itDoctor's Notes on Shiga Toxin E coli 0104H4 "Shiga" toxin is a strain of the Escherichia coli (E coli) bacteria that are commonly but they can cause infections when they spread to urine or bloodThe "Shiga" toxin can invade the lining of the gut and/or produce toxins that cause damage or secretory malfunctions of gut cells, which can cause watery or bloody diarrhea



Urinary Tract Infection Community Antibiotic Use Cdc
:max_bytes(150000):strip_icc()/Hot-Tub-Folliculitis-56ce4a425f9b5879cc60dd82-c3dc38001cb74645be21e3df8b86043e.jpg)


9 Common Bacterial Skin Infections
E coli is a bacteria found in the intestines of humans and all warmblooded animals Infections send more than 3,000 people to the hospital every year E coli symptoms include loss of appetite, nausea, gas and flatulence, chronic fatigue, sudden diarrhea that is very watery, and bloody stools Learn how NOT to get this bacterial infection!However, some strains may cause serious bacterial infections, leading to diarrhea and possible kidney failure Although there are no specific medications to "cure" the illness, there are measures youSigns & Symptoms Multistate Outbreak of Shiga toxinproducing Escherichia coli O157H7 Infections Linked to Ground Beef Skip directly to site content Skip directly to page options Skip directly to AZ link Skip directly to AZ link Skip directly to AZ link Centers for Disease Control and Prevention CDC twenty four seven



Erythema Multiforme Nhs


E Coli Infection
Doctor's Notes on Shiga Toxin E coli 0104H4 "Shiga" toxin is a strain of the Escherichia coli (E coli) bacteria that are commonly but they can cause infections when they spread to urine or bloodThe "Shiga" toxin can invade the lining of the gut and/or produce toxins that cause damage or secretory malfunctions of gut cells, which can cause watery or bloody diarrhea3 Rashes 4 High grade fever So possibility of gram negative bacterial infection is more In gram negative bacterias, E Coli and Pseudomonas have more chances as both can cause rashes with urine and abdominal infection So better to get done 1E coli is a bacteria found in the intestines of humans and all warmblooded animals Infections send more than 3,000 people to the hospital every year E coli symptoms include loss of appetite, nausea, gas and flatulence, chronic fatigue, sudden diarrhea that is very watery, and bloody stools Learn how NOT to get this bacterial infection!



Meningitis In Babies Symptoms And Treatment



Health Risks Associated With Bird Droppings Landmark Bird Control Bird Netting Bird Control Bird Netting New Jersey Commercial Bird Control Nj
People who get infected with E coli can have a wide range of symptoms You may not get sick at all If you do get sick, you may experience nausea;The most notorious type of pathogenic E coli is known as E coli 0157H7The name refers to the chemical compounds found on the surface of the bacterium This strain was identified in 19 following an outbreak of diarrhea resulting from the eating of undercooked beef The 0157H7 E coli strain belongs to a group of bacteria known as "Shiga toxinproducing" E coli, or STEC for shortAnd is one of the causes of food recalls and restaurantrelated food poisoning outbreaks



Bacterial Infections Of The Respiratory Tract Microbiology


Bacterial Skin Infection Dermatologist Medical Group Oceanside California
Depending on the bacterial subtype (determined by detection of certain surface antigens), other symptoms such17 later symptoms of signs and symptoms of E coli infections Hemorrhagic diarrhea (large amounts of blood in the stools) Anemia Pale skin color Severe dehydration Little or no urine output Severe abdominal pains Easy bruising Nosebleeds Fatigue Shortness of breathE coli (also termed Escherichia coli) is a gramnegative rodshaped bacterial species found worldwide;



Ehrlichiosis Symptoms Treatments Pictures And More



Fever And Rash Infectious Disease Advisor
UTIs are some of the most common infections doctors see Most are caused by E coli and are successfully treated with a round of antibiotics If you have symptoms of a UTI, see a doctor Most UTIsSymptoms of E coli are as follows Diarrhea, with or without blood Normal temperature typically, sometimes fever Feeling generally weak and achy (malaise) Abdominal painWatery or bloody diarrhea;



Skin Infection Pictures And Treatments



E Coli Infection Symptoms Causes And Treatment
E coli, or Escherichia coli, is a bacteria that is present mostly in the digestive systemThe bacteria is actually a normal flora of the intestines;Escherichia coli (E coli) is a bacteria that normally lives in the intestines of both healthy people and animals In most cases, this bacteria is harmless It helps digest the food you eat However, certain strains of E coli can cause symptoms including diarrheaEscherichia coli, or E coli, is a bacteria that inhabits the gut of humans as well as other animals, says Pritish Tosh, MD, an infectious disease physician and researcher at the Mayo Clinic Many



What Infections Aren T Contagious



Hives Pediatric Associates Of Northern Colorado Fort Collins Co
Entamoeba coli is a nonpathogenic species of Entamoeba that frequently exists as a commensal parasite in the human gastrointestinal tract E coli (not to be confused with the bacterium Escherichia coli) is important in medicine because it can be confused during microscopic examination of stained stool specimens with the pathogenic Entamoeba histolytica14 Warning Signs & Symptoms of E coli Escherichia coli is by far one of the most popular bacteria worldwide It is known by many patients, at least by name, and it is one of the most frequent causes of bacterial infections14 Warning Signs & Symptoms of E coli Escherichia coli is by far one of the most popular bacteria worldwide It is known by many patients, at least by name, and it is one of the most frequent causes of bacterial infections



Most Common Infectious Diseases In The U S In Pictures

Lecture 3 Diseases Caused By Bacterial Infection
Yes, sometimes The bad "e Coli" from food poisoning at first causes intestinal symptoms such as diarrhea If it goes on to damage the blood and the kidneys, more organs get affected, and skin rashes looking like tiny blood spots or like bruises can appear This second, serious stage of the illness is called hemolytic uremic syndromeSigns and symptoms of E coli O157H7 infection usually begin three or four days after exposure to the bacteria But you may become ill as soon as one day after exposure to more than a week later Signs and symptoms include Diarrhea, which may range from mild and watery to severe and bloody Stomach cramping, pain or tendernessEnterovirulent E coli (EEC) are bacteria that comprise several groups of E coli serovars, all of which may cause diarrhea and other problems in the intestines Facts EEC bacteria can cause a wide range of symptoms ranging from mild to bloody diarrhea, nausea, vomiting, stomach cramping and dehydrationDifferent groups often produce less (EAEC group) or more intense symptoms (EHEC group



Should You Be Worried About Germs In Your Swimming Pool Houston Methodist On Health



Urticaria
E coli is a type of bacteria normally found in intestines But certain kinds of E coli can cause infection and severe symptoms like diarrhea and dehydrationSymptoms appear within 1 to 10 days after exposure to E coli bacteria Most symptoms end within 5 to 10 daysE coli Streptococcus pneumoniae Listeria monocytogenes Neisseria meningitis Symptoms A patchy rash with lots of small red spots gathered in one area is the first sign One way to tell if it's a meningitis rash is by pressing a glass over it If the rash doesn't fade, it could be meningitis Other symptoms include



Petechial Rash In Children A Clinical Dilemma



Bowel Bypass Syndrome Dermnet Nz
It has many subtypes that may cause a variety of diseases in humans Usual signs and symptoms of E coli infections are nausea, vomiting, stomach cramps gas production and diarrhea;Hemolyticuremic syndrome (HUS) often occurs after a gastrointestinal infection with E coli bacteria (Escherichia coli O157H7) However, the condition has also been linked to other gastrointestinal infections, including shigella and salmonellaIt has also been linked to nongastrointestinal infectionsE coli is a bacteria found in the intestines of humans and all warmblooded animals Infections send more than 3,000 people to the hospital every year E coli symptoms include loss of appetite, nausea, gas and flatulence, chronic fatigue, sudden diarrhea that is very watery, and bloody stools Learn how NOT to get this bacterial infection!



Bacterial Infections Of The Skin And Eyes Microbiology



Racgp Common Rashes In Neonates
66 y/o Dr Oscar Novick answered 57 years experience PediatricsE coli infection can occur at any age, but young children and older adults are commonly affected Seek medical care if your child has diarrheal illnesses, to avoid dehydration and other complications Read this post to know more about the types, causes, symptoms, diagnosis, treatment, and prevention of E coli infection in childrenThis signs and symptoms information for Ecoli food poisoning has been gathered from various sources, may not be fully accurate, and may not be the full list of Ecoli food poisoning signs or Ecoli food poisoning symptoms Furthermore, signs and symptoms of Ecoli food poisoning may vary on an individual basis for each patient



Food Allergy Wikipedia


Lyme Disease Ontario County Ny Official Website
Symptoms of E coli Most people infected with Shiga toxinproducing E coli experience severe stomach cramps, diarrhea (often bloody), and vomiting Symptoms usually start 3 to 4 days after swallowing the bacteria14 Warning Signs & Symptoms of E coli Escherichia coli is by far one of the most popular bacteria worldwide It is known by many patients, at least by name, and it is one of the most frequent causes of bacterial infectionsIt is harmless and beneficial in most cases;



Necrotizing Fasciitis Symptoms Causes Flesh Eating Disease Treatment


Fever And Rash Infectious Disease And Antimicrobial Agents
One of the symptoms is a rash, which appears in three stages A blotchy red rash on the cheeks with groups of red papules After 4 days, a net of red marks may appear on the arms and trunkThe closely related E coli bacteria are generally neutral, or even beneficial, but a few strains are pathogenic, and can cause diarrhea Although most cases of E coli infection result in mild, foodpoisoninglike symptoms, E coli can give rise to hemolytic uremic syndrome, a disease similar to dysentery, and potentially lifethreateningEscherichia coli (E coli) Some types of Streptococcus People with sepsis often develop a hemorrhagic rash—a cluster of tiny blood spots that look like pinpricks in the skin If untreated, these gradually get bigger and begin to look like fresh bruises The symptoms of sepsis may look like other conditions or medical problems Always



Fever And Rash Infectious Disease Advisor
/infection-after-miscarriage-signs-and-symptoms-2371524-FINAL-abfac748318e4b39bb0e533a45890d80.png)


Avoid Sepsis After Miscarriage
Symptoms of Fifth Disease Bright red cheeks on both sides for 1 to 3 days Looks like "slapped cheeks" Followed by pink "lacelike" (netlike) rash of arms and legs "Lacy" rash mainly is on thighs and upper arms/shoulders Rash also is on chest and stomach in 50% of children The rash does not itch or hurt


The Impact Of Climate Change On Skin Dermnet Nz



Rashes And Fever In Children Sorting Out The Potentially Dangerous Part 1 Consultant360



Meningitis Symptoms Causes Types Treatment Risks More


E Coli What Is It How Does It Cause Infection Symptoms Causes



More Symptoms Of Coronavirus Covid Toes Skin Rashes Medical Disorders



Chlorine Rash Other Hot Tub Health Risks Hot Tub Health Benefits


Www Ohacep Org Aws Oacep Asset Manager Get File Ver



Measles Healthdirect



Contemporary Infectious Exanthems An Update Future Microbiology



Racgp Common Rashes In Neonates



Complications Of E Coli Infection About E Coli



Shingles Infections Msd Manual Consumer Version



Fever And Rash Infectious Disease Advisor



What Is Meningitis And What Are The Symptoms The Independent The Independent



Pathogens Free Full Text Bartonella Associated Cutaneous Lesions Bacl In People With Neuropsychiatric Symptoms



Skin Infection Pictures And Treatments



Chlorine Rash Other Hot Tub Health Risks Hot Tub Health Benefits



Urticaria


Fever And Rash Infectious Disease And Antimicrobial Agents



Gram Negative Folliculitis Dermnet Nz



Remission Of Aggressive Autoimmune Disease Dermatomyositis With Removal Of Infective Jaw Pathology And Ozone Therapy Review And Case Report Springerlink
:max_bytes(150000):strip_icc()/MRSA-wikimediacommons-56a6f7475f9b58b7d0e5bb1c-29e151963a384401849d2ae9dc56ced1.jpg)


9 Common Bacterial Skin Infections



The Rash That Wouldn T Quit Kara Fitzgerald Nd Naturopathic Doctor


3



E Coli Skin Page 1 Line 17qq Com



Rash Or Redness Widespread Pediatric Associates Of Northern Colorado Fort Collins Co



Skin Infection Pictures Causes And Treatments



Symptoms Of An E Coli Infection Everyday Health



Infections You Can Catch At The Gym Health Com



Rashes And Fever In Children Sorting Out The Potentially Dangerous Part 1 Consultant360



Strep Throat Treatment Do You Need An Antibiotic Everyday Health



Roseola Infantum And In Adults Evolution Of Rash Symptoms Treatment Contagious



Fever And Rash Infectious Disease Advisor


How E Coli Bacteria Can Harm Your Kidneys American Kidney Fund Akf



Pathogens Free Full Text Bartonella Associated Cutaneous Lesions Bacl In People With Neuropsychiatric Symptoms



Skin And Soft Tissue Infections American Family Physician



Skin Yeast Infection Home Remedies You Must Try Bliss Health Coaching


Q Tbn And9gcrcdsn163skp25lhlvve3snxrgs4bhkrw2oqy2hf6exyyrtl5wk Usqp Cau



Fever And Rash Infectious Disease Advisor



Ehrlichiosis Symptoms Treatments Pictures And More



Home Remedies For Rashes You Can Try Today



Cellulitis Wikipedia



Intestinal E Coli Infections Sepsis Alliance



Cat Scratch Disease Healthy Pets Healthy People Cdc



Contemporary Infectious Exanthems An Update Future Microbiology



It Started With A Rash The American Journal Of Medicine



Rash In Infants And Young Children Pediatrics Merck Manuals Professional Edition



Jarisch Herxheimer Reaction Wikipedia



Diphtheria Causes Symptoms And Diagnosis



Rash In Infants And Young Children Pediatrics Merck Manuals Professional Edition


Q Tbn And9gcrqk1d4xoom2oeijrqhwteo5dek5hckiclnye Vbwgfpx8q2ysd Usqp Cau



E Coli Lawyers Oft Food Safety Injury Lawyers



Diaper Rash Pediatric Adolescent Medicine Columbus Oh



Contemporary Infectious Exanthems An Update Future Microbiology



Escherichia Coli Extensive Cellulitis After Laparoscopic Radical Prostatectomy Sciencedirect



Rash In Infants And Young Children Pediatrics Merck Manuals Professional Edition



Gram Negative Folliculitis Dermnet Nz
:max_bytes(150000):strip_icc()/cellulitis-56ce46883df78cfb37a7e18f-31937815407b4d1ea65672c4a2f6148a.jpg)


9 Common Bacterial Skin Infections



Racgp Common Rashes In Neonates



Petechiae Definition Petechial Rash Causes Diagnosis Treatment



Pathogens Free Full Text Bartonella Associated Cutaneous Lesions Bacl In People With Neuropsychiatric Symptoms



Skin Manifestations Of Chronic Hepatitis C Virus Infection Infectious Disease Advisor


Q Tbn And9gcsldzqsdxvkszfv9uv7xw7hktyf4nzu6djifejjloja6d4ymqge Usqp Cau



Cat Scratch Fever Causes Symptoms And Diagnosis


Www Escmid Org Escmid Publications Escmid Elibrary Material Mid



Typhoid Fever Infections Msd Manual Consumer Version



Rash In Infants And Young Children Pediatrics Merck Manuals Professional Edition



Microbiology Case Study A 21 Month Old Boy With Diaper Rash And Diarrhea Lablogatory
:max_bytes(150000):strip_icc()/erysipelas4-6cf31d495e5e4b50bb8376fd3ae65cf3.jpg)


9 Common Bacterial Skin Infections



Faq What To Know About Dangerous Vibrio Bacteria



Hives Common Causes More Honorhealth



Fever And Rash Infectious Disease Advisor


コメント
コメントを投稿